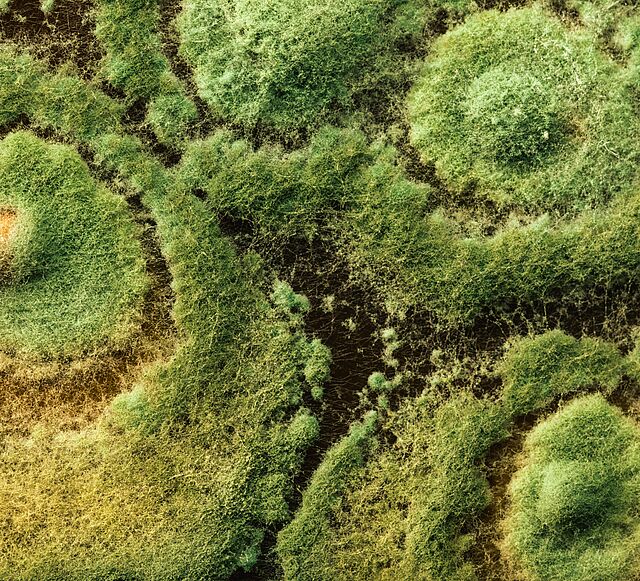

Wat is biologische bestrijding van ziekten?
Biologische bestrijding van plantenziekten is een methode die gebruikt wordt om plantenziekten te beheersen en de impact ervan te verminderen door gebruik te maken van nuttige organismen. Deze methode berust op het gebruik van levende organismen om ziekteverwekkers in planten te onderdrukken of te bestrijden, wat micro-organismen zijn die ziekten in planten veroorzaken. Het belangrijkste doel van biologische bestrijding is om de schade die deze ziekteverwekkers aanrichten te beperken en tegelijkertijd het gebruik van chemische bestrijdingsmiddelen en de bijbehorende milieurisico's te minimaliseren. Ziekten bij planten vormen een belangrijke bedreiging voor de wereldwijde voedselproductie. Ze kunnen leiden tot opbrengstverliezen, hogere productiekosten en milieuschade.
Nu we onder toenemende druk staan om duurzame en milieuverantwoorde landbouwpraktijken toe te passen, zal biologische bestrijding van ziekten een prominentere rol gaan spelen in onze systemen voor voedselproductie.
Ziekten bij planten begrijpen
Plantenziekten, veroorzaakt door verschillende ziekteverwekkers zoals schimmels, bacteriën en virussen, kunnen een ravage aanrichten in landbouwgewassen en siergewassen. Voor een succesvolle biologische bestrijding van ziekten is het van vitaal belang om te begrijpen hoe waardplanten en ziekteverwekkers nauw op elkaar inwerken. Deze kennis vormt de basis voor het ontwerpen van gerichte preventie- en bestrijdingsstrategieën.
Ziekten bij planten voorkomen
Effectieve preventie van ziekten bij planten omvat verschillende belangrijke praktijken.
Bewaking
Het is van vitaal belang om je planten regelmatig te controleren. Houd hun gezondheid en uiterlijk goed in de gaten. Let op ongewone tekenen, zoals vergelende bladeren, verwelking, ongebruikelijke groeipatronen, vlekken of laesies. Vroegtijdige opsporing maakt snel ingrijpen mogelijk en kan mogelijk voorkomen dat de ziekte zich verder verspreidt.
Teeltwisseling
Teeltwisseling is een fundamentele strategie, waarbij wordt vermeden om jaar na jaar hetzelfde gewas op dezelfde locatie te planten. Teeltwisseling verstoort ziektecycli en vermindert de opbouw van ziekteverwekkers in de bodem.
Ziekteresistente variëteiten
Een ander belangrijk aspect van preventie is het gebruik van ziekteresistente plantenvariëteiten. Kies voor plantenvariëteiten die specifiek zijn gekweekt op resistentie tegen ziekten. Deze rassen zijn inherent minder vatbaar voor veel voorkomende ziekten.
Gezonde bodem
Het onderhouden van een gezonde bodem is cruciaal. Grond die goed draineert en rijk is aan voedingsstoffen biedt een stevige basis voor planten om te gedijen. Gezonde planten zijn op hun beurt weerbaarder en beter uitgerust om ziekten te weerstaan.
Sanitaire voorzieningen
Tot slot speelt goede hygiëne een cruciale rol. Het verwijderen en tijdig afvoeren van ziek plantmateriaal is essentieel om de verspreiding van ziekteverwekkers te voorkomen. Deze praktijk is vooral belangrijk om de verspreiding van ziekten binnen je gewas tegen te gaan.
Behandeling: Ziekten bij planten bestrijden
Wanneer preventie en vroegtijdige detectie tekortschieten, is het cruciaal om effectieve behandelingsstrategieën tot je beschikking te hebben.
Biofungiciden
Biofungiciden bieden een natuurlijke en milieuvriendelijke oplossing voor de bestrijding van schimmelziekten. Deze biofungiciden werken via verschillende mechanismen die gezamenlijk bijdragen aan een beter ziektebeheer en een gezonder gewas. Ze concurreren beter dan ziekteverwekkers om ruimte en voedingsstoffen, parasiteren op ziekteverwekkers en versterken de afweer van planten. Biofungiciden bevorderen een robuuste plantengroei, vooral onder stressvolle omstandigheden, en maken essentiële voedingsstoffen beter toegankelijk voor planten. Deze natuurlijke alternatieven voor chemische fungiciden verbeteren de gezondheid van de bodem, verhogen de productiviteit van gewassen en dragen bij aan een duurzaam milieu.
Voordelen van biologische bestrijding van ziekten
Duurzaamheid en milieuvoordelen
Voortdurende afhankelijkheid van chemische bestrijdingsmiddelen kan leiden tot de ontwikkeling van resistente ziekten. Biologische bestrijding helpt deze cyclus te doorbreken door een duurzaam alternatief te bieden.
Minder chemische residuen
Biologische bestrijding vermindert de behoefte aan chemische bestrijdingsmiddelen, wat leidt tot minder chemische residuen op gewassen en producten. Dit verbetert niet alleen de veiligheid van landbouwproducten, maar komt ook tegemoet aan de groeiende bezorgdheid over residuen van bestrijdingsmiddelen in voeding.
Behoud van nuttige organismen
In tegenstelling tot chemische bestrijdingsmiddelen zijn biologische bestrijdingsmethoden niet schadelijk voor nuttige insecten, waardoor een bloeiend ecosysteem ontstaat dat natuurlijke plaagbestrijding en ziektebestrijding bevordert.
Veelgestelde vragen
-
Wat is het beheer van plantenziekten en waarom is het essentieel voor telers en boeren?
Het beheer van plantenziekten omvat strategieën om ziekten in gewassen te voorkomen, te identificeren en te behandelen. Het is van cruciaal belang om gezonde oogsten te garanderen en economische verliezen door ziekten te minimaliseren.
-
Wat zijn de belangrijkste voordelen van biologische bestrijding?
Biologische bestrijding van ziekten zorgt voor minder milieubelasting, behoud van nuttige organismen en voordelen op het gebied van resistentiemanagement.
-
Hoe kun je ziekten bij planten voorkomen?
Praktijken zoals teeltwisseling, het gebruik van ziekteresistente variëteiten en het gezond houden van de grond met de juiste voedingsstoffen en drainage kunnen ziekten helpen voorkomen.
-
Welke rol spelen nuttige organismen bij biologische bestrijding van ziekten?
Nuttige micro-organismen, zoals bepaalde bacteriestammen en schimmels, werken als antagonisten tegen ziekteverwekkers in planten. Ze produceren verbindingen of enzymen die de groei van ziekteverwekkende micro-organismen remmen en zo hun aanwezigheid effectief onderdrukken.
-
Kan biologische bestrijding chemische bestrijdingsmiddelen volledig vervangen?
Hoewel het de afhankelijkheid van chemische bestrijdingsmiddelen aanzienlijk kan verminderen, hangt de volledige vervanging af van verschillende factoren, zoals het type gewas en de ziektedruk.
-
Is biologische bestrijding van ziekten een kosteneffectieve methode voor telers?
De initiële implementatiekosten kunnen variëren, maar na verloop van tijd is het meestal kosteneffectief vanwege de toegenomen kwaliteit en gewasopbrengsten.